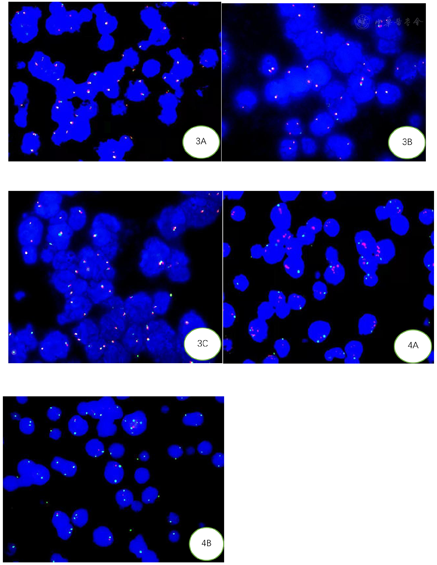

患者,男性,67岁。大便次数增加1年余,脐周隐痛不适3个月余。
大便次数增加,4~10次/d,每次量不多,3个月前出现脐周隐痛不适。CT检查考虑阑尾恶性肿瘤伴腹膜、网膜及肝脏多发转移。
B超引导下肝脏结节穿刺活检,病理常规切片、免疫组化标记及分子生物学检测。
给予R-Hyper CVAD part A方案化疗。
患者经6疗程化疗后腹盆腔肿块及肝结节基本消失,随访至今恢复良好。
病理科;血液科

版权归中华医学会所有。本文为遵循CC-BY-NC-ND协议的开放获取文章。
伴11q异常的Burkitt样淋巴瘤(Burkitt-like lymphoma with11qaberration,BLL-11q)是WHO淋巴造血系统肿瘤分类(2017年修订版)增加的一个临时性淋巴瘤类型[1]。其形态学及免疫表型类似于Burkitt淋巴瘤(Burkitt lymphoma,BL),但缺乏MYC基因重排而伴11q特征性改变(11q23.2-23.3增多和11q24.1-qter端粒缺失)。该肿瘤较罕见,国内有28例报道[2,3,4,5],国外有80余例报道[2,6,7,8,9]。以肝脏穿刺活检组织诊断的病例国外仅1例报道[6],国内未见报道。本文报道1例经肝脏穿刺诊断的BLL-11q,旨在提高对本病的进一步认识,减少误诊和探讨治疗规范。
患者,男性,67岁。因大便次数增加1年余,脐周隐痛不适3个月余就诊。患者1年前无明显诱因下出现大便次数增加,4~10次/d,每次量不多,无黑便,无呕吐,无畏寒发热等,当时未予重视,未诊治。3个月前无明显诱因下出现脐周隐痛不适,不剧能忍。患者无家族遗传性疾病和肿瘤病史,无冶游史,无手术史,无免疫缺陷病史。
血常规:白细胞4.25×109/L,红细胞4.12×1012/L,血小板279×109/L。乳酸脱氢酶(LDH)214 U/L。血肿瘤指标无异常。2021年01月29日我院全腹CT提示右下腹占位,考虑阑尾恶性肿瘤伴腹膜、网膜及肝脏多发转移(图1A)。2021年02月03日B超检查右肝前叶下段1.89 cm×1.61 cm实性低回声团,边界清(图1C)。2021年3月12日PET-CT检查:肝脏、右下腹部软组织团块影,包绕回盲部,最大截面6.6 cm×9.4 cm,SUV最大值30.3;肝包膜缘、腹盆腔系膜及网膜均放射性摄取明显增高(图1D)。骨髓细胞学涂片及活检均未见明显异常。


2021年02月03日行肝脏结节穿刺活检,肿瘤组织弥漫浸润性生长,肿瘤细胞中等大,形态单一,胞质少,嗜碱性,核染色质细颗粒状,偶见小核仁,少量肿瘤细胞较大,可见明显核仁,星空现象明显,散在组织细胞吞噬凋亡小体及核碎片,部分吞噬达6个凋亡小体,颗粒较粗大,见散在嗜酸粒细胞、残存胆管及周边变性肝细胞。免疫组化标记:CD20,CD10,BCL6及LMO2均阳性,MYC(阳性,70%),Ki-67增殖指数>95%(图2)。CD3,BCL2,MUM1,TDT,CD30,CD38,CyclinD1,EBER,CK(pan)均阴性。FISH检测MYC基因、BCL2基因及BCL6基因,计数肿瘤细胞200个,未见红绿信号分离的细胞,结果均为阴性(图3)。FISH检测11号染色体显示11q23扩增,11q24缺失(图4)。




伴11q异常的Burkitt样淋巴瘤(BLL-11q),Ⅳ期A组IPI评分4分,高危组。
Burkitt淋巴瘤,高级别B细胞淋巴瘤及弥漫大B细胞淋巴瘤。
患者接受R-Hyper CVAD part A方案化疗。(利妥昔单抗700 mg d0,CTX 0.57 g Q12H d1-3,地塞米松40mg d1-4、11-14,多柔比星脂质体55 mg d4,长春地辛4 mg d4,11)d0-d4化疗,辅以护胃、止呕、碱化水化治疗。
随访7个月余,已完成6个疗程化疗。化疗3个疗程后,CT示右下腹部肿瘤明显缩小,与右侧腰大肌分界明显。化疗6个疗程后,PET-CT示腹盆腔腹膜系膜未见明显肿块及异常FDG代谢增高灶,肝脏未见明显放射性摄取增高(图1),现患者恢复良好。
BLL-11q自命名以来不断有病例报道,但以个案和小宗病例分析为主,其发病率和临床表现等数据非常有限。该肿瘤发病年龄较广,从2~83岁,但以年轻患者多见,中位年龄11岁[2,7]。在18岁以下儿童和青少年中,BLL-11q比BL、高级别B细胞淋巴瘤(HGBCL)及弥漫大B细胞淋巴瘤(DLBCL)相对年长,中位年龄13.9岁[7],男性多于女性。该肿瘤国外报道好发于淋巴结[7],国内报道不一,谢建兰等[2]报道以结外尤其是鼻咽部多见,张延平等[3]报道6例均为头颈部淋巴结。除颈部、腹部、后腹膜及盆腔淋巴结外,乳腺、回盲肠,扁桃体、骨及软组织,睾丸等均有报道,可侵犯肝脏及胰腺,产生胸腹水[6,7,10,11]。这可能与病例数和人种有关,也可能因疾病分期晚,结外及结内均受累而无法准确区分。肿块大小变化较大,最大径从2~11 cm[3],还有报道肿块>20 cm[12]。血LDH可以正常或轻度升高[7,12]。临床Ann Arbor分期多为Ⅰ/Ⅱ期,Ⅲ/Ⅳ期的较少[2,3,7]。除免疫功能正常者外,在AIDS、器官移植及免疫抑制的情况下均有报道[8,11]。本例患者肝脏、右下腹部软组织、回盲部、腹盆腔系膜及网膜均受肿瘤累及,临床Ⅳ期A组IPI评分4分,属高危组。
形态学上,肿瘤细胞呈弥漫性生长为主,类似BL、或介于BL和DLBCL之间,可有一定程度的细胞多形性,偶尔呈结节状[1,2,3]。Horn等[9]首次提出当组织细胞吞噬5~9个凋亡小体和颗粒较粗的凋亡碎片,推测11q异常的特异性91%,灵敏度85%。这已被Yu等[6]证实,强调当>50%的组织细胞吞噬较多的凋亡小体及颗粒较粗的凋亡碎片可预测11q异常。本患者虽为穿刺小组织,但也观察到这种形态改变,证实其强烈的提示作用。推测11q可能存在特定的机制驱动凋亡频率的增加,但具体分子机制还需进一步研究证实[9]。
BL典型的免疫表型是CD20+,CD10+,BCL2-,Ki-67>90%。11q阴性和11q阳性病例CD10、BCL6、MUM1, Ki-67和MYC蛋白表达均无明显差异,但11q阳性的病例比阴性的病例更多的BCL2阴性,差异有统计学意义[9]。免疫组化检测表明[2],BL显示LMO2阴性而CD38阳性,BLL-11q显示LMO2阳性而缺乏CD38高表达。流式细胞学检测表明CD16/CD56阳性支持BLL-11q[12]。本病例也证实这组免疫表型可以快速有效的提示BLL-11q,并指导进一步的分子生物学检测。
BLL-11q容易与一些高侵袭性B细胞淋巴瘤混淆。鉴别诊断:⑴BL:两者形态学和免疫表型均有重叠[1,13],但BL存在MYC基因重排。⑵HGBCL伴双打击/三打击淋巴瘤即伴MYC和BCL-2和/或BCL-6易位的高级别B细胞淋巴瘤:鉴别主要依靠分子遗传学检测,文献报道少数MYC基因易位阳性的高级别B细胞淋巴瘤中也可出现11q的异常[10]。BLL-11q的诊断要求缺乏MYC、BCL-2及BCL-6的易位。⑶DLBCL(生发中心起源):可出现11q大片段的获得或扩增,而非11q近端区域的获得伴远端区域的缺失[13]。因11q异常不是BLL-11q所特有,其他侵袭性淋巴瘤如BL和MYC阳性或阴性的HGBL、DLBCL中也存在[7,9,10]。所以分子检测顺序是先做MYC基因重排,当MYC基因重排阴性再做11q染色体检测。只有综合形态学、免疫表型和分子生物学检测才能正确诊断。本病例检测MYC、BCL-2及BCL-6均未见易位,检测到11q23增多和11q24缺失而明确诊断。
现有报道该肿瘤预后较好,经化疗后大多完全缓解,生存率94.74%~100%[2,3,7,12],有报道术后未行放化疗随访47个月无病生存[2],合并AIDS的1例患者拒绝放化疗随访34月没有复发及新病灶[8]。本病例确诊前病程达1年余,临床Ⅳ期A组IPI评分4分,高危组,经化疗后随访7月余,腹盆腔肿块及肝结节均消失,患者恢复良好。故可考虑BLL-11q为单独的淋巴瘤亚型,在治疗上降低化疗剂量[2,7],防止过度治疗,但还须要更多的病例队列研究及同一阶段/危险度的临床比较来确定最佳治疗方案。
所有作者均声明本研究不存在利益冲突